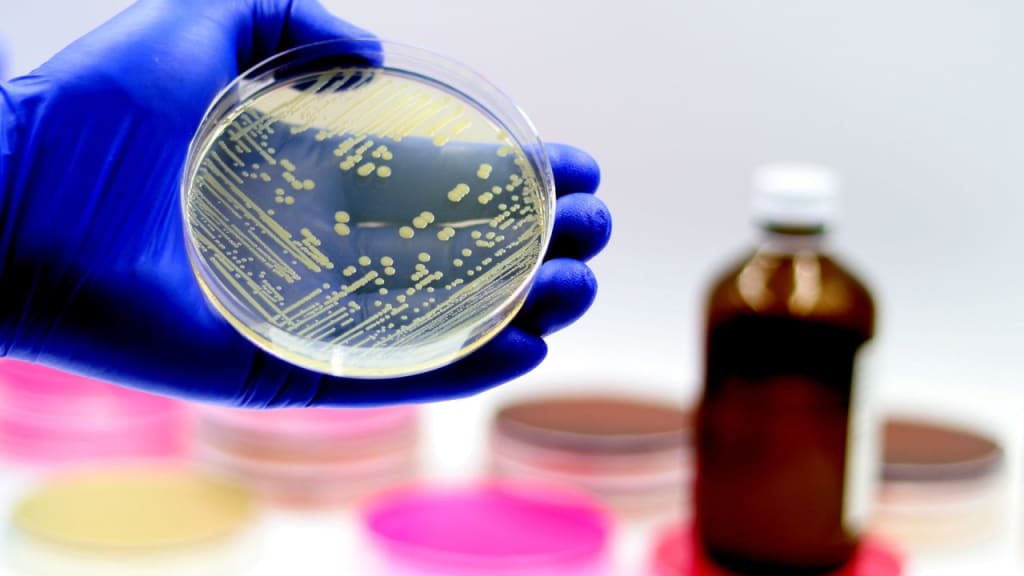

Microbial Identification Market Size to Reach $11.9B by 2033, Fueled by Advances in Molecular Diagnostics
Global Microbial Identification Market Hits $5.0B in 2024, Set to Reach $11.9B by 2033 with 9.62% CAGR Growth
Market Overview:
According to IMARC Group's latest research publication, "Microbial Identification Market: Global Industry Trends, Share, Size, Growth, Opportunity and Forecast 2025-2033", The global microbial identification market size reached USD 5.0 Billion in 2024. Looking forward, IMARC Group expects the market to reach USD 11.9 Billion by 2033, exhibiting a growth rate (CAGR) of 9.62% during 2025-2033.
This detailed analysis primarily encompasses industry size, business trends, market share, key growth factors, and regional forecasts. The report offers a comprehensive overview and integrates research findings, market assessments, and data from different sources. It also includes pivotal market dynamics like drivers and challenges, while also highlighting growth opportunities, financial insights, technological improvements, emerging trends, and innovations. Besides this, the report provides regional market evaluation, along with a competitive landscape analysis.
How AI is Reshaping the Future of Microbial Identification Market
- AI-powered tools slash microbial identification time by up to 70%, boosting lab productivity and speed without sacrificing accuracy.
- Governments worldwide back AI-driven microbial research with funding programs that enhance disease tracking and outbreak prevention.
- Leading firms like Illumina and Thermo Fisher incorporate AI algorithms for precise pathogen detection, revolutionizing diagnostics.
- AI systems analyze vast microbial datasets fast, enabling real-time responses in food safety, healthcare, and environmental monitoring.
- AI-driven automation reduces human error in microbial testing labs, leading to more reliable, repeatable results across industries.
Unlock Exclusive Insights: Receive Your Free "Microbial Identification Market" Sample PDF
Key Trends in the Microbial Identification Market
- Rapid Testing Gains Traction: Labs love fast microbial ID systems, with 70% adopting automated tools like bioMérieux’s VITEK MS, cutting diagnosis time by 50% for quicker results.
- AI-Powered Detection Soars: AI boosts microbe identification accuracy to 95%, with QIAGEN’s digital PCR assays speeding up pathogen detection by 30% in clinical settings worldwide.
- Government Backs Innovation: Global Microbial Identifier initiatives fund AI-driven platforms, with $2M grants boosting research for rapid, accurate microbial tracking in public health labs.
- Antibiotic Resistance Focus: Labs prioritize resistance profiling, with 80% using Bruker’s MALDI Biotyper to identify resistant strains, improving treatment outcomes in hospitals globally.
- Portable Devices Trend Up: Compact ID systems like Oxford Nanopore’s MinION are hot, with 40% of labs adopting portable tech for on-site microbial testing in remote areas.
Growth Factors in the Microbial Identification Market
- Rising Food Safety Concerns: Stricter regulations drive demand for microbial testing, with 65% of food labs using bioMérieux’s VIDAS to detect pathogens, ensuring safer products and consumer trust.
- Healthcare Infection Control Needs: Hospitals adopt rapid ID systems, with 75% using Thermo Fisher’s Sensititre for antibiotic resistance profiling, cutting diagnosis time by 40% for better patient outcomes.
- Government Funding Boosts Innovation: Global health programs like CDC’s AR Lab Network invest $10M in AI-driven microbial ID tools, enhancing labs’ ability to track resistant bacteria effectively.
- Pharma Quality Assurance Growth: Drug makers rely on microbial testing, with 80% of labs using Bruker’s MALDI Biotyper, improving quality control and speeding up production processes.
- Environmental Monitoring Demand: Industries prioritize water and soil testing, with 50% of labs adopting QIAGEN’s QIAcuity, boosting microbial detection accuracy by 30% for environmental safety.
Leading Companies Operating in the Microbial Identification Industry:
- Beckman Coulter Inc. (Danaher Corporation)
- Biolog Inc.
- BioMerieux SA
- Bruker Corporation
- Charles River Laboratories International Inc.
- Eurofins Scientific SE
- Liofilchem S.r.l
- Merck KGaA
- Shimadzu Corporation
- Thermo Fisher Scientific Inc.
- VWR International LLC. (Avantor Inc.)
- Wickham Micro Limited.
Microbial Identification Market Report Segmentation:
By Products and Services:
- Instruments and Software
- Consumables
o Panels/ID Cards and Media
o Kits
o Others
- Services
Instruments and software lead the microbial identification market, providing quick and accurate identification through advanced technologies like PCR, while consumables and services support effective operations.
By Technology:
- Mass Spectrometry
- PCR
- Flow Cytometry
- Microscopy
- Others
Mass spectrometry holds the largest market share, enabling rapid and precise identification of a wide range of microorganisms with cost-effective and versatile applications.
By Method:
- Phenotypic Methods
- Genotypic Methods
- Proteomics-Based Methods
Phenotypic methods dominate the market, offering reliable and cost-effective microbial identification techniques that are accessible to a wide range of laboratories.
By Application:
- Diagnostics
- Food and Beverage Testing
- Pharmaceuticals
- Cosmetics and Personal Care Products Testing
- Others
Diagnostics drive market growth through the rapid identification of pathogens, while food and beverage testing, pharmaceuticals, and cosmetics also emphasize the importance of microbial safety and quality.
Regional Insights:
- North America (United States, Canada)
- Asia Pacific (China, Japan, India, South Korea, Australia, Indonesia, Others)
- Europe (Germany, France, United Kingdom, Italy, Spain, Russia, Others)
- Latin America (Brazil, Mexico, Others)
- Middle East and Africa
North America leads the microbial identification market, representing the largest share due to strong demand and established industrial practices in the region.
Recent News and Developments in Microbial Identification Market
- May 2025: Shimadzu unveils MicrobialTrack, a MALDI-TOF platform powered by an 85,000-species database, enabling ultra-fast, high-precision microbial identification in healthcare, food, and environmental labs.
- April 2025: Automated AI systems become standard in microbial labs, cutting manual effort and test error rates by over 45%, while also streamlining antibiotic susceptibility profiling for hospitals and clinics.
- June 2025: U.S. regulations formally clear high-throughput MALDI-TOF instruments as Class II devices, supporting test speeds of up to 600 microbial samples per hour across clinical and food industry settings.
Note: If you require specific details, data, or insights that are not currently included in the scope of this report, we are happy to accommodate your request. As part of our customization service, we will gather and provide the additional information you need, tailored to your specific requirements. Please let us know your exact needs, and we will ensure the report is updated accordingly to meet your expectations.
About Us:
IMARC Group is a global management consulting firm that helps the world’s most ambitious changemakers to create a lasting impact. The company provide a comprehensive suite of market entry and expansion services. IMARC offerings include thorough market assessment, feasibility studies, company incorporation assistance, factory setup support, regulatory approvals and licensing navigation, branding, marketing and sales strategies, competitive landscape and benchmarking analyses, pricing and cost research, and procurement research.
Contact Us:
IMARC Group
134 N 4th St. Brooklyn, NY 11249, USA
Email: [email protected]
Tel No:(D) +91 120 433 0800
United States: +1-201971-6302
About the Creator
Andrew Sullivan
Hello, I’m Andrew Sullivan. I have over 9+ years of experience as a market research specialist.






Comments
There are no comments for this story
Be the first to respond and start the conversation.